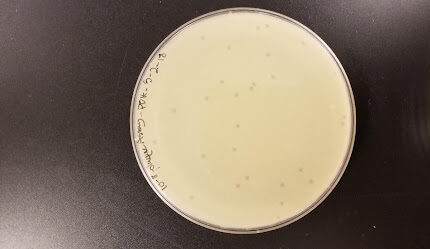

I returned from a conference in Washington, DC recently. It’s an event I look forward to every year.
I got to spend nearly four days talking with people who love bacteriophages (phages) as much as I do! Because I’m still on a scientific high from the meeting I can’t resist the opportunity to blog about bacteriophages. Don’t expect some profound theological insight. I simply want to see if I can get you to appreciate this curious, tiny piece of God’s amazing creation and to experience the awe and wonder I have the privilege of experiencing regularly when I work in the laboratory—a gift I never take for granted.
What are bacteriophages? Phages are viruses that infect bacteria. They are tiny, you need an electron microscope to visualize them. They are exceedingly abundant. Scientists estimate that there are 10,000,000,000,000,000,000,000,000,000,000 (1031) on our planet. I don’t know about you, but I can’t wrap my head around that number! They seem to occupy every ecological niche that bacteria do—water, soil, your gut, and more.

Phages are not cellular. They require a bacterial cell (host) to replicate, and they can replicate in two ways. Some phages are lytic—they infect a bacterium, hijack the bacterial cell’s machinery to make hundreds of copies of themselves, then they cause the bacterial cell to burst so the copies can go on to infect neighboring bacterial cells, killing the original cell in the process.
Other phages are temperate—they infect a bacterium, then plug their genome into the DNA genome of the host bacterial cell. Their genome gets replicated along with the host for many generations until some environmental trigger leads to the phage genome hopping out of the bacterial genome and going through the lytic cycle leading to host bursting and infecting neighboring cells.
We study bacteriophages that infect soil bacteria. We find them by mixing extracts from soil samples with bacteria and plating the mixture in a semi-solid medium. We call this a bacterial lawn because after a day or so, the bacteria will form a cloudy, visible layer—except where a phage was present. Anywhere a single infectious phage was present, it will infect a bacterial cell, make lots of copies, burst the cell, infect neighbors, and so on. This infection cycle forms a “plaque” or clearing in the bacterial lawn where the bacteria in that area have been killed by the phage.
Why study bacteriophages?
Phage genomes are relatively simple. The phages I work with have genomes with 50-400 genes (compared to the human genome’s 25,000). Scientists, including me, are actively studying phage genomes because they provide an accessible system for understanding evolutionary processes.
Phages and bacteria are engaged in an ongoing cat and mouse evolutionary battle. Bacteria evolve systems to prevent phage infection and phages evolve systems to evade bacterial defenses. These defense and evasive systems are being studied extensively by scientists and have been co-opted for use in the laboratory. Enzymes that cut DNA at specific sequences (restriction endonucleases), plasmids, and CRISPR/Cas are examples of these naturally occurring systems that scientists now routinely use directly or in modified fashion for cloning, gene editing, gene inactivation, and more.
Phages are also used for phage therapy. While phage therapy was first studied 100 years ago, enthusiasm for this method of treating bacterial infections waned with the discovery of antibiotics. Antibiotics were easy, inexpensive, and had the ability to kill a broad range of bacteria. However, phage therapy has once again become an area of intense study with the emergence of antibiotic-resistant infections.

Lytic phages are excellent bacterial killers. They have no ability to infect human (or any eukaryotic) cells. So, if scientists can find a phage, or preferably a cocktail of several phages, that can infect the bacteria causing an antibiotic-resistant infection, treating a patient with phages will kill the problematic bacteria, clear the infection, and cause no harm to the patient. Phage therapy works as recounted in Stephanie Strathdee’s riveting memoir, The Perfect Predator and reported by CNN.
I collaborate with two groups, both sponsored by the Howard Hughes Medical Institute, called SEA-PHAGES and SEA-GENES. One goal of this work is to find phages that will clear antibiotic resistant tuberculosis infections and infections by the bacterium Mycobacterium abscessus, a notoriously antibiotic-resistant bacterium that often plagues people who get a lung transplant. The work has been successful in clearing around half of all antibiotic-resistant infections they’ve tried.
Phage therapy is even being used to try to prevent and cure colony collapse in honeybees.
I find all these reasons to study bacteriophages compelling. As a Christian, I also find studying bacteriophages to be intrinsically valuable because they are a part of God’s good creation. When I make a discovery, I’m going to share it. That’s what scientists do.
For a moment, however, I share a small bit of knowledge about the natural world with God alone. It’s an intimate, personal glimpse inside God’s journal. I feel awe and wonder. It’s an experience of worship for me. Perhaps a peek into the wonderful world of bacteriophages has given you a reason to experience awe and wonder too.
12 Responses
Thank you Sara for this “glimpse inside God’s journal.” And thank you scientists for good work.
Absolutely, Sara. I always look forward to these.
Thank you, Sara. I too am filled with “awe and wonder”.
Just before reading this blog I saw a view from the Vera C. Rubin Observatory of the Virgo cluster approximately 65 million light years from the Milky Way. Wow, the details of the micro and the macro came to me in one morning! What an amazing Creator God we worship. She/he cannot be limited!
I love this so much! What a great experience you had! As often as possible I attend a talk at a conference that covers macro–something I’m much less familiar with. I never cease to walk away amazed!
Wonderful stuff! And lucidly written for the non-scientist. Thanks so much.
Sara,
Simply amazing! And delighted to learn that Northwestern College was the incubator for so many amazing discoveries!
Thank you.
Thanks for sharing this, Sara! I hear about phages at work, but I was as surprised to read about them here! Thanks for making the worlds collide. (Greetings from International Livestock Research Institute in Nairobi.)
I love hearing from a fellow scientist! Best wishes on your work!
Thank you for another fascinating peek into your world of science, Sara. Besides feeling a little better-prepared for Jeopardy, I love to see someone so obviously enjoying using their gifts and working in a field where they have been called. Keep ’em coming!
It is sobering to consider where we would be without scientific research. Thank you Sara. I hope you find encouragement for your work here! Please keep writing.